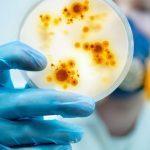

The All Progressives Congress (APC) campaign for the September 19 Edo Governorship election would be a subject of irony over workers’ welfare.
This is as two members of the APC Campaign Council and Governors, Hope Uzodinma and Yahaya are having issues with payment of workers’ salaries while Governor Godwin Obaseki, the Peoples Democratic Party (PDP) candidate which they campaign against has paid Edo workers up to date.
The 49-member APC Edo Governorship Election Campaign Council chaired by Governor Abdullahi Ganduje of Kano State has the Imo State Governor, Uzodinma as Vice Chairman with the Kogi State farm, Bello as a member.
The Campaign Council which would be inaugurated on Monday by the Mai-Mala Buni-led Caretaker/Extra-Ordinary National Convention Planning Committee is to principally sell the candidature of the party’s flagbearer, Osagie Ize-Iyamu to the people of Edo State.
READ ALSO: Edo election update: Results so far
The irony, according to pundits is how Uzodimma would face the people of Edo and campaign against Obaseki when he is owing owning workers in his State three months’ salaries arrears and other emoluments? According to the organized Labour in Imo, they have been owed salaries from February to April when Uzodinma assumed office as Governor after Supreme Court sacked Emeka Ihedioha of the PDP who was paying salaries and arrears owed by the APC administration of Rochas Okorocha.
As the Imo State Chairman of Nigeria Labour Congress (NLC), Austin Chilakpu recently lamented, despite the directive by Governor Uzodimma for workers’ salaries to be paid before the end of every month, they were yet to receive salaries since February to April 2020.
Chilakpu stated that workers in primary and secondary schools in the state, as well as those in nineteen parastatals and agencies, were affected in unpaid salaries.
He listed the affected agencies where workers were owed three months salary arrears as: “Imo Broadcasting Corporation (IBC), Agriculture Development Programme (ADP), Imo State Water Corporation, Imo State Poverty Alleviation Bureau, primary and secondary school teachers”.
Others are: “Imo State University, Imo State Polytechnic, Imo State Library Board, Imo State Universal Basic Education Board, Imo State Secondary Education Board, Imo Tourism Board, etc”.
It is also surprising how Governor Bello who has not paying Kogi State workers full salaries would tell Edo State workers to vote out Obaseki who has paid full salaries up to date.
Though the Kogi State Governor had claimed to be up to date in the payment of salaries after receiving N30.8 billion bailout funds from the Federal Government, BusinessDay learned that the salaries are not paid fully and in some cases the amount paid is ridiculous.
READ ALSO: Edo election has re-united South-South more – Obaseki
Speaking to BuisnessDay, a Labour official from the State who pleaded anonymity for the fear of the unknown, said the State civil servants are paid only 80% salaries while Local Government and Primary School Teachers are paid between 10-20%.
“He is giving percentages. Sometimes I begin to wonder, do we have Federal Government at all, won’t they come and investigate? As a Local Government Staff at Grade Level 10 you are taking 15,000 – 17,000. Is it done elsewhere?
“He has been paying State Civil Servants but since the last five months, he is not paying them full again. The state is now 80 percent. He is paying them up to date but with percentage.
“But Local Government and Education Authority, you don’t even know the amount they are paying you, just stipends. Somebody whose salary is up to N100,000 will take home N20, 000 and sometimes N22, 000.
“We have counterparts from Benue State on Grade Level 12 who are taking N1000, 000 and above and we are taking N20, 000. That is what we are facing”, the Labour Official lamented.
READ ALSO:Edo election: Buhari, Tinubu, Wike, Oshiomhole left no lessons, Ondo will prove it
Reacting to the development, a political activist/analyst from Edo, Daniel Lawani said it is laughable that APC Governors who have not paid salaries in their States and have corruption issues would step into Edo to campaign against Obaseki.
Lawani said apart from been update with salary payment, Obaseki has performed very well and does not have any corruption case, stressing that he is above most of the APC Governors, especially those in the Campaign Council.
“Imagine the Governor who has paid from January to now. How many of these APC Governors have paid salaries up to date? The Imo State Governor who is the Deputy Chairman of the APC Campaign Council is owning months of salary.
“Even Yahaya Bello is not paying full salaries. What then can they tell Edo people especially the workers. Will they tell them to vote APC, a party that its Governors don’t pay salaries? Edo people will not even listen to their lies and will not vote their candidate (Ize-Iyamu) who also has many corruption cases hanging on his neck”, he maintained.